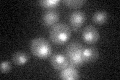
YMR213W
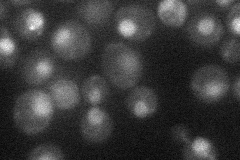
YMR213W
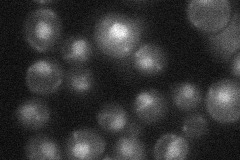
YMR213W
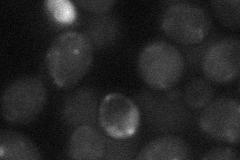
YMR213W

View description
Essential splicing factor; associated with Prp19p and the spliceosome, contains an N-terminal c-Myb DNA binding motif necessary for cell viability but not for Prp19p association, evolutionarily conserved and homologous to S. pombe Cdc5p
Localization:
Intensity:
Fold change:
Significance:
-
C’ GFP library in SD
nucleus21.71 -
N' NOP1pr-GFP in SD
nucleus23.9415 -
N' TEF2pr-mCherry in SD

nucleus55.1906 -
N' NATIVEpr-GFP in SD
nucleus25.3949 -
N' TEF2pr-VC and Cyto-VN in SD
below threshold21.8923 -
C’ GFP library in SD+DTT

nucleus24.531.12No -
C’ GFP library in SD+H2O2

nucleus19.40.89No -
C’ GFP library in Starvation Media

nucleus24.461.12No -
C’ GFP library on the background of Pup2-DaMP

nucleus -
C’ GFP library on the background of CCT mutant

nucleus23.8131.0968No
